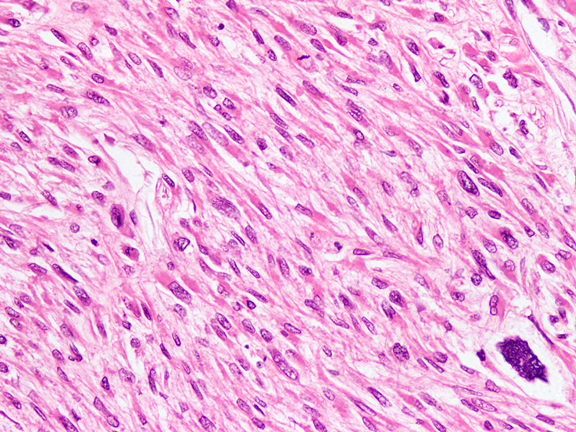

Table of Contents
Definition / general | Essential features | Pathophysiology | Diagrams / tables | Clinical features | Interpretation | Uses by pathologists | Prognostic factors | Microscopic (histologic) description | Microscopic (histologic) images | Virtual slides | Positive staining - normal | Positive staining - disease | Negative staining | Sample pathology report | Additional references | Practice question #1 | Practice answer #1 | Practice question #2 | Practice answer #2Cite this page: Qureshi MB, Ud Din N. Desmin. PathologyOutlines.com website. https://www.pathologyoutlines.com/topic/stainsdesmin.html. Accessed August 26th, 2025.
Definition / general
- 52kDa cytoplasmic intermediate filament present in muscle and endothelial cells (Braz J Med Biol Res 2004;37:1819)
- Expressed in neoplasms with myogenic differentiation
- Variable expression in myofibroblasts
Essential features
- Good screening marker for neoplasms with myogenic differentiation (including rhabdomyosarcoma, rhabdomyoma, leiomyosarcoma, leiomyoma, smooth muscle and rhabdomyoblastic elements in other tumors)
- Used in combination with myogenin / MyoD1 to confirm myogenic differentiation (Ann Diagn Pathol 2018;36:50)
- Cytoplasmic positivity in general with perinuclear dot positivity in desmoplastic small round cell tumor
- Expressed in genital stromal tumors (including fibroepithelial stromal polyp, aggressive angiomyxoma and angiomyofibroblastoma)
- Expressed in rare fibrohistiocytic and myofibroblastic tumors (including angiomatoid fibrous histiocytoma and low grade myofibroblastic sarcoma)
Pathophysiology
- Maintains structural and functional integrity of muscle cells
- Forms cytoskeletal network across muscle fibers, localized to the subplasmalemmal region and Z band
- Important role in mitochondrial functioning (Int J Mol Sci 2020;21:8122)
Clinical features
- Mutations in the desmin gene (DES) cause desmin related myopathy (DRM) (ESC Heart Fail 2020;7:1338)
Interpretation
- Cytoplasmic staining
- Perinuclear dot-like positivity in certain tumors (Am J Surg Pathol 2014;38:1220)
Uses by pathologists
- Screening immunomarker for myogenic differentiation
- Focal positivity in myofibroblastic tumors
- Differentiates smooth muscle tumors (desmin+) from gastrointestinal stromal tumor (3 - 5% desmin+) (Ann Diagn Pathol 2007;11:39)
- Differentiates pleomorphic rhabdomyosarcoma (desmin+) from undifferentiated pleomorphic sarcoma (desmin-) (Ann Diagn Pathol 2018;37:118)
- Differentiates rhabdomyosarcoma (desmin+) from extrarenal rhabdoid tumor (desmin-) (Ann Diagn Pathol 1998;2:351)
- Differentiates embryonal / pleomorphic rhabdomyosarcoma (desmin+) from proliferative fasciitis / myositis (desmin-) (APMIS 1992;100:437)
- Differentiates spindle cell rhabdomyosarcoma (desmin+) from infantile fibrosarcoma (desmin-) (J Pediatr Hematol Oncol 2008;30:723)
- Helps differentiate sclerosing rhabdomyosarcoma (desmin+) from sclerosing epithelioid fibrosarcoma (desmin-) (Zhonghua Bing Li Xue Za Zhi 2004;33:337)
- Differentiates rhabdomyoma (desmin+) from congenital granular cell epulis (desmin-) (Head Neck Pathol 2020;14:208)
- Differentiates rhabdomyoma (desmin+) from granular cell tumor (desmin-) (Am J Surg Pathol 1998;22:779)
- Differentiates rhabdomyoma (desmin+) from crystal storing histiocytosis (desmin-) (Head Neck Pathol 2012;6:111)
- Differentiates aggressive angiomyxoma / angiomyofibroblastoma (desmin+) from cellular angiofibroma (5% desmin+) (Diagn Pathol 2015;10:114)
- Differentiates mammary type myofibroblastoma (desmin+) from spindle cell lipoma (16% desmin+), cellular angiofibroma (5% desmin+) and solitary fibrous tumor (desmin-)
- Differentiates angiomatoid fibrous histiocytoma (desmin+) from aneurysmal fibrous histiocytoma (desmin-) (Histopathology 1995;26:323)
- Differentiates reactive mesothelial proliferation (85% desmin+) from malignant mesothelioma (10% desmin+) (Histopathology 2003;43:231)
Prognostic factors
- Potent oncofetal diagnostic and prognostic biomarker in colorectal cancer (Mol Cell Proteomics 2009;8:1878)
- Myogenic differentiation (desmin and smooth muscle actin) expression is a poor prognostic factor in dedifferentiated liposarcoma (Am J Surg Pathol 2020;44:799)
- Predictor of survival in moderately differentiated leiomyosarcoma (Histopathology 2015;66:627)
Microscopic (histologic) description
- Perinuclear dot positivity in desmoplastic round cell tumor and sclerosing rhabdomyosarcoma
- Dendritic process-like staining along with cytoplasmic expression in angiomatoid fibrous histiocytoma
Microscopic (histologic) images
Contributed by Nasir Ud Din, M.B.B.S.
Positive staining - normal
- Myoblasts, myofibroblasts (variable), myometrium, smooth muscle cells (Cell Struct Funct 1997;22:103)
- Mesothelial cells (reactive) (Cancer Cytopathol 2010;118:90)
- Cervix: decidual reaction, endometrium (focal), fallopian tube stroma (Histopathology 1996;29:437)
- Liver: stellate cells (J Anat 2000;197:635)
Positive staining - disease
- Skeletal muscle tumors, including rhabdomyosarcomas, rhabdomyomas (100%) (Am J Clin Pathol 1990;93:305)
- Skeletal muscle components in other tumors, including rhabdomyoblastic elements in malignant triton tumor (100%), rhabdomyosarcoma component in ectomesenchymoma (100%), rhabdomyoblastic differentiation in dedifferentiated liposarcoma (100%) (Medicine (Baltimore) 2019;98:e16797, Zhonghua Bing Li Xue Za Zhi 2018;47:94)
- Smooth muscle tumors, including leiomyosarcomas (70 - 80%), leiomyomas (100%), smooth muscle hamartoma (100%), Epstein Barr virus associated smooth muscle tumor (50%)
- Smooth muscle component in myolipoma (100% in spindle cells) (Am J Surg Pathol 2017;41:153)
- Fibroblastic / myofibroblastic tumors, including aggressive angiomyxoma (100%, focal to diffuse), angiomyofibroblastoma (75 - 100%), myofibroblastoma (91 - 100%), low grade myofibroblastic sarcoma (67%), fibromatosis (up to 50%), inflammatory myofibroblastic tumor (33.3%), ischemic fasciitis (40%), fibroepithelial stromal polyp (92%) (Hum Pathol 2008;39:846, Semin Diagn Pathol 2021;38:85, J Cutan Pathol 2015;42:441)
- Fibrohistiocytic tumors, including:
- Angiomatoid fibrous histiocytoma (78%) (J Clin Pathol 2014;67:210)
- Localized / diffuse type tenosynovial giant cell tumor (43%) (Mod Pathol 1998;11:939)
- Tumors of uncertain differentiation, including:
- Ossifying fibromyxoid tumor (13 - 38%) (Arch Pathol Lab Med 2019;143:1504)
- Intimal sarcoma (variable focal positive) (Zhonghua Bing Li Xue Za Zhi 2020;49:816)
- Desmoplastic small round cell tumor (100%) (Zhonghua Bing Li Xue Za Zhi 2005;34:650)
- Extraskeletal mesenchymal chondrosarcoma (50%) (Ann Diagn Pathol 2010;14:8)
- Extraskeletal osteosarcoma (variable) (Am J Surg Pathol 1998;22:588, Zhonghua Bing Li Xue Za Zhi 2021;50:44)
- Alveolar soft part sarcoma (50%) (Mod Pathol 1996;9:496)
- PEComa (weak to moderate, focal positive, 85%) (Int J Clin Exp Pathol 2019;12:4380)
- Lipoblastoma (immature mesenchymal spindle cells) (Pathol Int 2013;63:353)
- Spindle cell lipoma (16%) (Virchows Arch 2004;445:354)
- Inflammatory fibroid polyp (variable) (In Vivo 2021;35:81)
- EWSR1-PATZ1 sarcoma (78%) (Mod Pathol 2021;34:770)
- Undifferentiated embryonal sarcoma of liver (50%) (Arch Pathol Lab Med 2015;139:269)
- Biphenotypic sinonasal sarcoma (39%) (J Neurol Surg B Skull Base 2019;80:51)
- Endometrial stromal sarcoma (77%) (Gynecol Oncol 2004;92:71)
Negative staining
- Adipocytic tumors, including myxoid liposarcoma
- Fibroblastic / myofibroblastic tumors, including nasopharyngeal angiofibroma, nodular fasciitis (few scattered cells), myxoinflammatory fibroblastic sarcoma, myxofibrosarcoma, low grade fibromyxoid sarcoma, sclerosing epithelioid fibrosarcoma, fibroma of tendon sheath, desmoplastic fibroma, angiofibroma of soft tissue, cellular angiofibroma, solitary fibrous tumor, intranodal palisaded myofibroblastoma (occasionally positive), dermatomyofibroma, dermatofibrosarcoma protuberans, nuchal type fibroma (Iran J Pathol 2016;11:195, Arch Pathol Lab Med 2007;131:306, Oncol Lett 2016;11:661)
- Pediatric fibroblastic / myofibroblastic tumors, including inclusion body fibromatosis, giant cell fibroblastoma, calcifying fibrous tumor, fibrous hamartoma of infancy, infantile fibrosarcoma
- Fibrohistiocytic / histiocytic / dendritic cell tumors, including dermatofibroma, cellular neurothekoma, reticulohistiocytoma, crystal storing histiocytosis, plexiform fibrohistiocytic tumor, follicular dendritic cell sarcoma
- Pericytic tumors, including glomus tumor, myopericytoma, myofibroma, myofibromatosis, sinonasal glomangiopericytoma
- Vascular tumors, including pseudomyogenic hemangioendothelioma, epithelioid hemangioendothelioma, angiosarcoma (Zhonghua Bing Li Xue Za Zhi 2018;47:45, Arch Pathol Lab Med 2020;144:529)
- Neural tumors, including perineurioma, dermal nerve sheath myxoma, glial heterotropia, malignant peripheral nerve sheath tumor, epithelioid malignant peripheral nerve sheath tumor, schwannoma, granular cell tumor, ganglioneuroma (Am J Surg Pathol 1998;22:779)
- Tumors of uncertain differentiation, including intramuscular myxoma, superficial angiomyxoma (occasional focal positive), acral fibromyxoma, pleomorphic hyalinizing angiectatic tumor, hemosiderotic fibrolipomatous tumor, atypical fibroxanthoma, myoepithelioma of soft tissue (0 - 20%), phosphaturic mesenchymal tumor, synovial sarcoma, epithelioid sarcoma, extrarenal rhabdoid tumor (Head Neck Pathol 2015;9:32, Cureus 2020;12:e12263)
- Undifferentiated pleomorphic sarcoma
- Myeloid sarcoma
- Gastrointestinal stromal tumor (Virchows Arch 2004;445:142, Transl Gastroenterol Hepatol 2018;3:27)
- Malignant gastrointestinal neuroectodermal tumor
- Congenital granular cell epulis
- Ovarian fibroma
- Melanotic neuroectodermal tumor of infancy
- Primary pulmonary myxoid sarcoma
Sample pathology report
- Vagina, excision biopsy:
- Botryoid embryonal rhabdomyosarcoma
- Polypoid fragments lined by squamous epithelium with subepithelial condensation of round blue cells
- Deep dermis and subcutaneum show diffuse sheets and aggregates of round to spindle strap cells with frequent mitoses
- Diffuse desmin and focal myogenin positivity supports the diagnosis of botryoid embryonal rhabdomyosarcoma
- Botryoid embryonal rhabdomyosarcoma
Additional references
Practice question #1
A 20 year old man presented with a palpable abdominal mass of 10 cm. Microscopy revealed a tumor with distinct nests of small round blue cells in a desmoplastic stroma. Tumor cells were positive for immunostains cytokeratin AE1 / AE3, desmin and WT1 (C terminus). Immunostains LCA, TdT, synaptophysin, MyoD1 and myogenin were negative. Which stain is shown in the image in context with this tumor?
- Cytokeratin (AE1 / AE3)
- Desmin
- EMA
- Myogenin
- WT1
Practice answer #1
Practice question #2
What is the most common pattern of desmin immunostaining in rhabdomyosarcoma?
- Cytoplasmic staining
- Dendritic process-like staining
- Golgi staining
- Nuclear staining
- Perinuclear staining
Practice answer #2